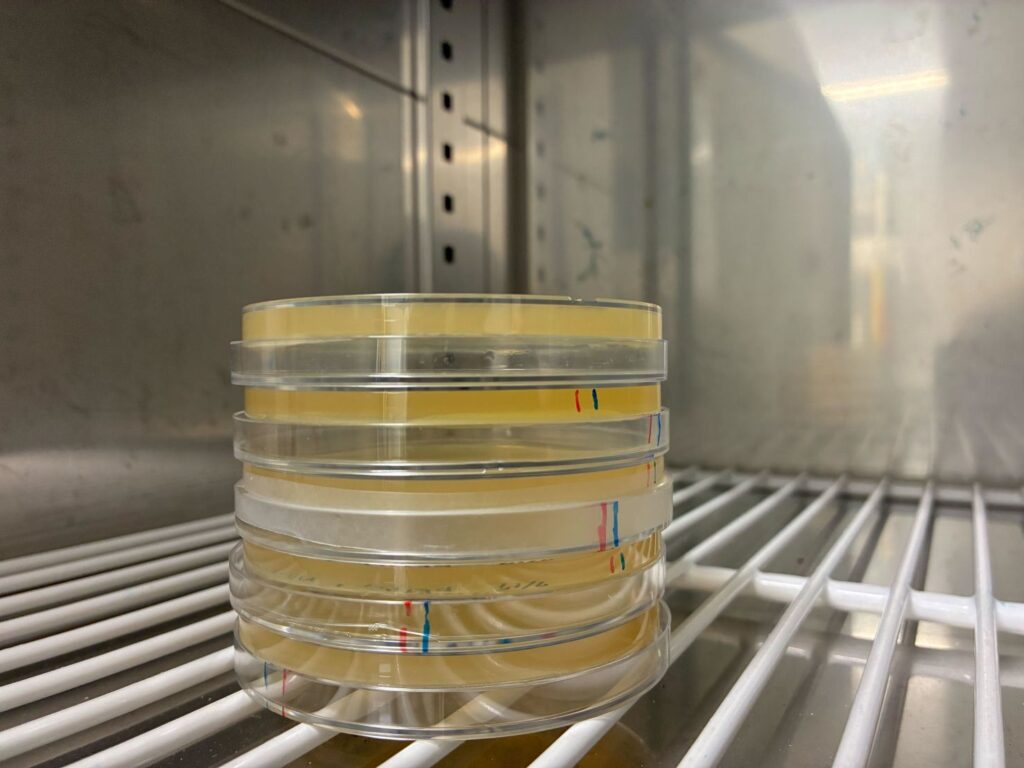

JP
ありえた生命をつくって
生命を理解する
生命を理解する
木賀研究室は、遺伝子工学の発展形である合成生物学を手段とし、
生命の起源の理学的探求から、生物の設計手法の確立による産業応用までを行います。

木賀研究室
Kiga Lab.
お知らせ
News
-

<オープンハウス 教員対応時間変更>
カテゴリー
-

ホームページをリニューアルしました!
カテゴリー
-

2025夏合宿
カテゴリー

研究紹介
Research
アミノ酸の種類が変化したタンパク質の人工進化
生命がなぜ現在の20種類のアミノ酸を用いているのか、という問いは、生命の起源やアストロバイオロジーに関わる根源的な疑問です。私たちはこの問いを探究すると同時に、新しいタンパク質工学への応用を目指しています。
タンパク質をAIでデザイン
同一機能を持つタンパク質について、様々な生物由来で少しずつ異なる配列がデータベースに多数登録されています。
バイオDX: 発想に対応した人工遺伝子回路を自動生成
ゲノム情報の蓄積と、DNA合成技術の進展により、複数の遺伝子を組み合わせた「人工遺伝子回路」の構築が容易になってきました。
生命誕生のカギとなる分子を再現
RNAワールドに存在したリボザイムなど、生命誕生の初期段階で鍵となる生体高分子を再現し、その機能を明らかにすることで、生命の起源に迫っています。
研究業績
Achievement
仲間募集
Recruit
木賀研究室では先進理工学部 電気情報生命工学科の学部生、院生、
博士課程後期学生および博士研究員を募集しています
早稲田大学 理工学術院
先進理工学部 電気・情報生命工学科
木賀研究室 Kiga Lab.
E-mail kiga@waseda.jp
TEL 03-5369-7314
FAX 03-5369-7314